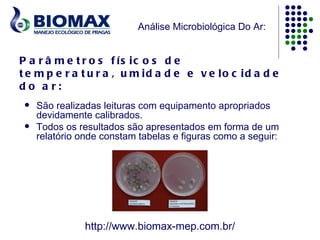
Análise Microbiológica Do Ar:


P a r â m e t r o s f ís ic o s d e
t e m p e r a t u r a , u m id a d e e v e lo c id a d e
do a r:
    São realizadas leituras com equipamento apropriados
     devidamente calibrados.
    Todos os resultados são apresentados em forma de um
     relatório onde constam tabelas e figuras como a seguir:




                http://www.biomax-mep.com.br/

O documento aborda a análise microbiológica do ar em ambientes climatizados, destacando a importância da avaliação da qualidade do ar e da poluição, especialmente em relação à síndrome do edifício doente. São detalhados métodos de coleta e análise de contaminantes microbiológicos e químicos, bem como histórico e regulamentações pertinentes à saúde ocupacional. A Biomax é apresentada como uma empresa especializada nesse tipo de análise, atendendo diversos setores como saúde e hotelaria.